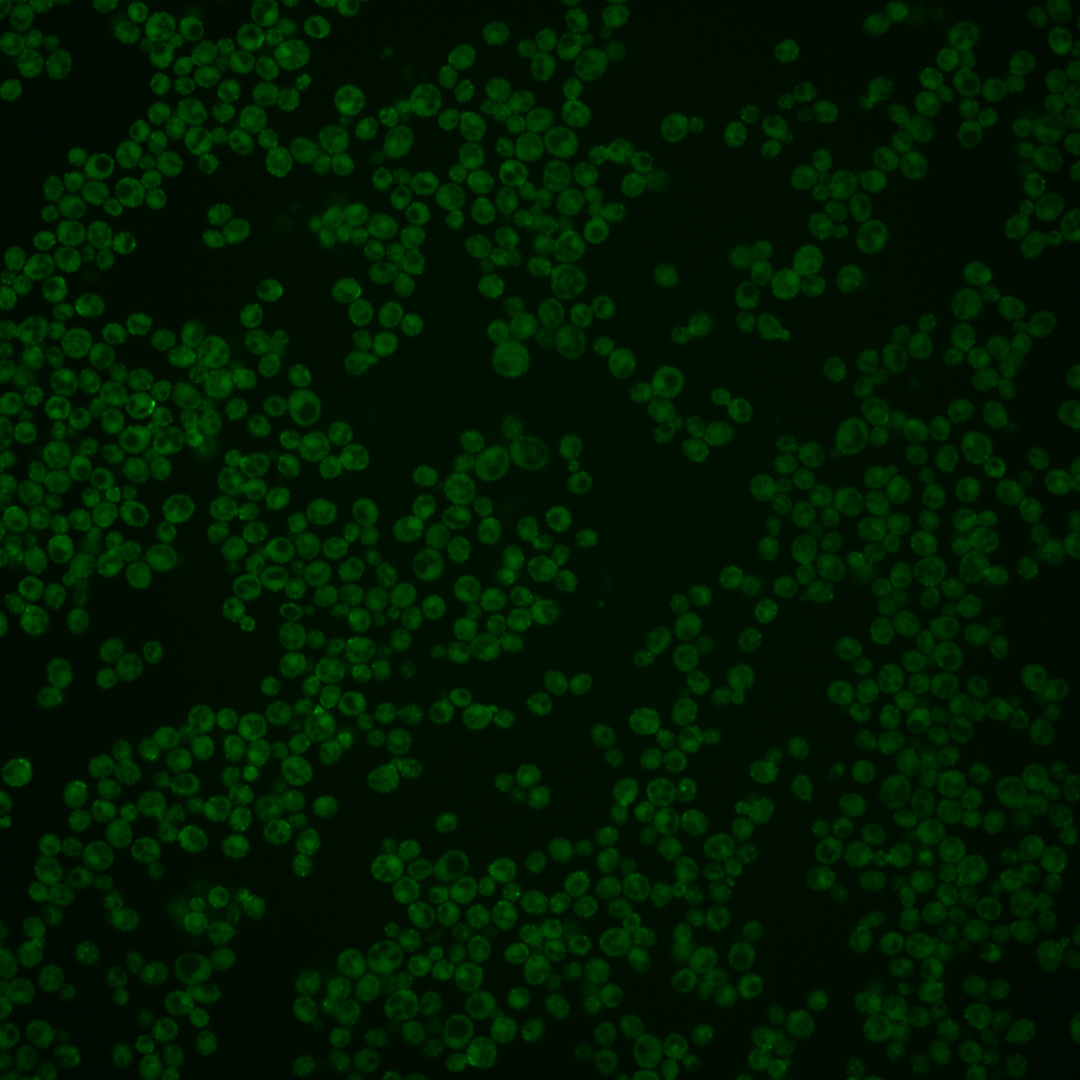
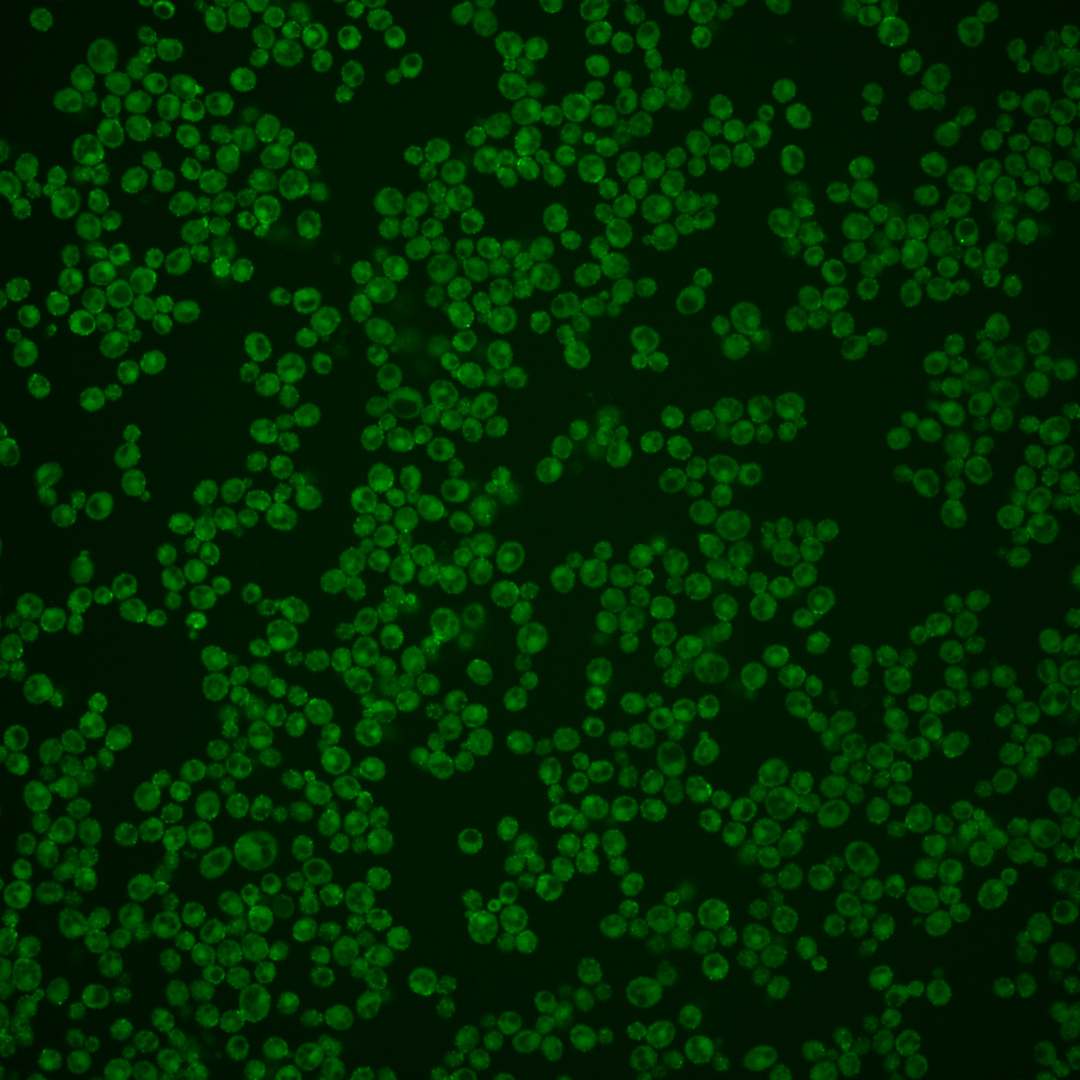
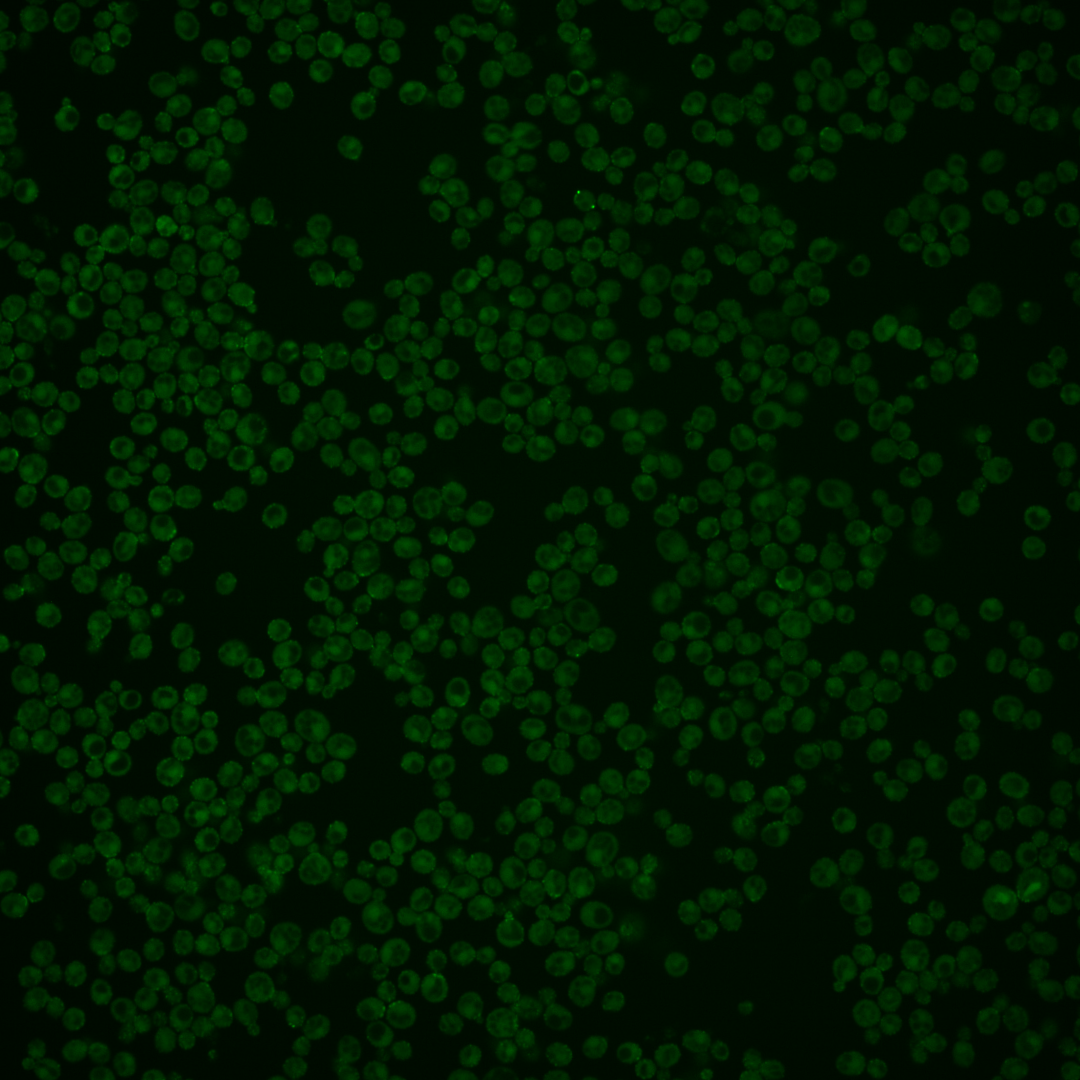

| Standard name | |
|---|---|
| Human Ortholog | |
| Description | Epsin-like protein required for endocytosis and actin patch assembly; functionally redundant with Ent1p; contains clathrin-binding motif at C-terminus; ENT2 has a paralog, ENT1, that arose from the whole genome duplication |
Micrographs




















































































Sub-cellular Localization
Yeast GFP Assignment
Protein Abundance
Localization Change
External localization resources
| ensLOC | DeepLoc | |||||||||||||||||||||||
|---|---|---|---|---|---|---|---|---|---|---|---|---|---|---|---|---|---|---|---|---|---|---|---|---|
| Localization | WT1 | WT2 | WT3 | RAP60 | RAP140 | RAP220 | RAP300 | RAP380 | RAP460 | RAP540 | RAP620 | RAP700 | HU80 | HU120 | HU160 | rpd3Δ_1 | rpd3Δ_2 | rpd3Δ_3 | WT1 | WT2 | WT3 | AF100 | AF140 | AF180 |
| Cortical Patches | 75 | 108 | 59 | 30 | 39 | 55 | 64 | 68 | 67 | 49 | 57 | 51 | – | 5 | 3 | 55 | 43 | 37 | 229 | 315 | 129 | 17 | 33 | 43 |
| Bud | 25 | 26 | 6 | 7 | 13 | 16 | 25 | 22 | 32 | 15 | 26 | 16 | – | 1 | 1 | 11 | 11 | 11 | 8 | 9 | 6 | 0 | 3 | 2 |
| Bud Neck | 0 | 0 | 0 | 0 | 0 | 0 | 0 | 0 | 0 | 0 | 0 | 0 | – | 0 | 0 | 0 | 1 | 0 | 25 | 42 | 21 | 0 | 4 | 4 |
| Bud Site | 4 | 2 | 0 | 0 | 0 | 1 | 3 | 2 | 2 | 3 | 0 | 1 | – | 0 | 0 | 0 | 2 | 1 | – | – | – | – | – | – |
| Cell Periphery | 29 | 109 | 30 | 23 | 19 | 26 | 31 | 32 | 16 | 18 | 23 | 34 | – | 3 | 10 | 15 | 11 | 7 | 27 | 55 | 14 | 3 | 2 | 3 |
| Cytoplasm | 207 | 243 | 104 | 78 | 122 | 105 | 115 | 118 | 94 | 87 | 88 | 91 | – | 18 | 53 | 50 | 46 | 46 | 65 | 72 | 34 | 2 | 3 | 6 |
| Endoplasmic Reticulum | 52 | 149 | 53 | 41 | 34 | 56 | 61 | 66 | 64 | 46 | 62 | 42 | – | 6 | 18 | 6 | 3 | 7 | 25 | 44 | 15 | 2 | 2 | 6 |
| Endosome | 14 | 0 | 0 | 0 | 1 | 7 | 13 | 10 | 13 | 5 | 5 | 3 | – | 0 | 3 | 10 | 6 | 21 | 10 | 8 | 13 | 1 | 3 | 3 |
| Golgi | 1 | 1 | 2 | 0 | 3 | 3 | 4 | 9 | 7 | 5 | 9 | 11 | – | 0 | 0 | 19 | 22 | 11 | 4 | 6 | 1 | 0 | 0 | 1 |
| Mitochondria | 4 | 1 | 0 | 2 | 0 | 12 | 11 | 5 | 51 | 25 | 69 | 50 | – | 0 | 0 | 3 | 2 | 4 | 8 | 6 | 8 | 0 | 1 | 2 |
| Nucleus | 3 | 1 | 1 | 1 | 0 | 0 | 1 | 2 | 3 | 2 | 1 | 1 | – | 0 | 0 | 0 | 0 | 0 | 0 | 0 | 0 | 0 | 0 | 0 |
| Nuclear Periphery | 0 | 0 | 0 | 0 | 0 | 0 | 0 | 0 | 0 | 1 | 0 | 0 | – | 0 | 0 | 0 | 0 | 0 | 1 | 0 | 0 | 0 | 0 | 1 |
| Nucleolus | 2 | 0 | 0 | 0 | 0 | 2 | 2 | 0 | 1 | 1 | 0 | 3 | – | 0 | 0 | 1 | 4 | 2 | 0 | 0 | 0 | 0 | 0 | 0 |
| Peroxisomes | 1 | 1 | 0 | 0 | 0 | 3 | 0 | 3 | 2 | 4 | 1 | 2 | – | 0 | 0 | 1 | 6 | 8 | 1 | 0 | 3 | 0 | 0 | 4 |
| SpindlePole | 2 | 4 | 4 | 0 | 11 | 13 | 20 | 29 | 23 | 7 | 3 | 7 | – | 1 | 0 | 37 | 42 | 41 | 3 | 0 | 1 | 0 | 1 | 0 |
| Vac/Vac Membrane | 5 | 8 | 3 | 0 | 7 | 17 | 27 | 21 | 42 | 34 | 24 | 30 | – | 0 | 0 | 12 | 16 | 12 | 11 | 9 | 3 | 0 | 1 | 0 |
| Unique Cell Count | 345 | 498 | 208 | 148 | 207 | 245 | 295 | 294 | 319 | 229 | 271 | 248 | 28 | 72 | 169 | 159 | 152 | 427 | 577 | 256 | 32 | 63 | 87 | |
| Labelled Cell Count | 424 | 653 | 262 | 182 | 249 | 316 | 377 | 387 | 417 | 302 | 368 | 342 | 34 | 88 | 220 | 215 | 208 | 427 | 577 | 256 | 32 | 63 | 87 | |
Yeast GFP Assignment
Protein Abundance
| Screen | WT1 | WT2 | WT3 | RAP60 | RAP140 | RAP220 | RAP300 | RAP380 | RAP460 | RAP540 | RAP620 | RAP700 | HU80 | HU120 | HU160 | rpd3Δ_1 | rpd3Δ_2 | rpd3Δ_3 | AF100 | AF140 | AF180 |
|---|---|---|---|---|---|---|---|---|---|---|---|---|---|---|---|---|---|---|---|---|---|
| Mean Cell GFP Intensity (1e-4) | 8.4 | 11.1 | 9.6 | 9.2 | 10.8 | 10.0 | 10.0 | 10.4 | 8.8 | 9.4 | 8.8 | 9.6 | – | 11.6 | 11.3 | 16.1 | 16.3 | 14.9 | – | – | 10.5 |
| Std Deviation (1e-4) | 1.3 | 1.7 | 1.2 | 1.3 | 1.6 | 1.8 | 1.7 | 1.9 | 1.9 | 1.8 | 2.0 | 2.4 | – | 1.9 | 1.5 | 3.9 | 3.8 | 3.3 | – | – | 1.8 |
| Intensity Change (Log2) | – | – | – | -0.05 | 0.17 | 0.06 | 0.06 | 0.12 | -0.13 | -0.03 | -0.12 | 0.01 | – | 0.28 | 0.24 | 0.75 | 0.76 | 0.64 | – | – | 0.13 |
Localization Change
| Localization | RAP60 | RAP140 | RAP220 | RAP300 | RAP380 | RAP460 | RAP540 | RAP620 | RAP700 | HU80 | HU120 | HU160 | rpd3Δ_1 | rpd3Δ_2 | rpd3Δ_3 |
|---|---|---|---|---|---|---|---|---|---|---|---|---|---|---|---|
| Cortical Patches | -1.7 | -2.3 | -1.4 | -1.7 | -1.3 | -1.9 | -1.7 | -1.9 | -1.9 | – | -1.2 | -4.3 | 0.9 | -0.3 | -0.9 |
| Bud | 0.9 | 1.7 | 1.8 | 2.6 | 2.2 | 3.1 | 1.8 | 2.9 | 1.8 | – | 0 | 0 | 1.7 | 1.8 | 1.9 |
| Bud Neck | 0 | 0 | 0 | 0 | 0 | 0 | 0 | 0 | 0 | – | 0 | 0 | 0 | 0 | 0 |
| Bud Site | 0 | 0 | 0 | 0 | 0 | 0 | 0 | 0 | 0 | – | 0 | 0 | 0 | 0 | 0 |
| Cell Periphery | 0.3 | -1.7 | -1.2 | -1.3 | -1.2 | -3.7 | -2.2 | -2.1 | -0.2 | – | 0 | -0.1 | -1.7 | -2.3 | -3.0 |
| Cytoplasm | 0.5 | 1.8 | -1.5 | -2.5 | -2.2 | -4.8 | -2.5 | -3.9 | -2.9 | – | 1.4 | 3.5 | -4.0 | -4.1 | -3.8 |
| Endoplasmic Reticulum | 0.5 | -2.3 | -0.7 | -1.3 | -0.8 | -1.5 | -1.3 | -0.7 | -2.2 | – | -0.5 | -0.1 | -5.8 | -6.2 | -5.2 |
| Endosome | 0 | 0 | 0 | 3.1 | 0 | 2.9 | 0 | 0 | 0 | – | 0 | 0 | 0 | 0 | 5.5 |
| Golgi | 0 | 0 | 0 | 0 | 0 | 0 | 0 | 0 | 2.2 | – | 0 | 0 | 4.3 | 4.9 | 3.2 |
| Mitochondria | 0 | 0 | 3.2 | 0 | 0 | 6.1 | 4.9 | 7.9 | 6.9 | – | 0 | 0 | 0 | 0 | 0 |
| Nucleus | 0 | 0 | 0 | 0 | 0 | 0 | 0 | 0 | 0 | – | 0 | 0 | 0 | 0 | 0 |
| Nuclear Periphery | 0 | 0 | 0 | 0 | 0 | 0 | 0 | 0 | 0 | – | 0 | 0 | 0 | 0 | 0 |
| Nucleolus | 0 | 0 | 0 | 0 | 0 | 0 | 0 | 0 | 0 | – | 0 | 0 | 0 | 0 | 0 |
| Peroxisomes | 0 | 0 | 0 | 0 | 0 | 0 | 0 | 0 | 0 | – | 0 | 0 | 0 | 0 | 0 |
| SpindlePole | 0 | 1.9 | 1.9 | 2.5 | 3.5 | 2.7 | 0.8 | 0 | 0.6 | – | 0 | 0 | 6.2 | 7.0 | 7.1 |
| Vacuole | 0 | 0 | 2.8 | 3.6 | 2.9 | 4.7 | 5.0 | 3.5 | 4.4 | – | 0 | 0 | 2.8 | 3.7 | 3.0 |
External localization resources
Images






























Protein Concentration and Protein Localization Data
| R1 | R2 | R3 | ||||||||||||||||
|---|---|---|---|---|---|---|---|---|---|---|---|---|---|---|---|---|---|---|
| G1 Pre-START | G1 Post-START | S/G2 | Metaphase | Anaphase | Telophase | G1 Pre-START | G1 Post-START | S/G2 | Metaphase | Anaphase | Telophase | G1 Pre-START | G1 Post-START | S/G2 | Metaphase | Anaphase | Telophase | |
| Concentration | 4.8452 | 5.9226 | 5.5315 | 4.3859 | 4.1501 | 5.5871 | 6.1241 | 7.0026 | 6.4127 | 5.9262 | 5.5532 | 6.6143 | 6.2364 | 6.853 | 5.8683 | 6.1245 | 5.6411 | 6.7494 |
| Actin | 0.3517 | 0.3351 | 0.4803 | 0.3315 | 0.4003 | 0.4441 | 0.4607 | 0.3547 | 0.4527 | 0.5082 | 0.3655 | 0.4151 | 0.5902 | 0.4137 | 0.5677 | 0.5635 | 0.5 | 0.4559 |
| Bud | 0.0041 | 0.0022 | 0.0094 | 0.0018 | 0.0032 | 0.0101 | 0.0021 | 0.0055 | 0.0043 | 0.0019 | 0.0069 | 0.0032 | 0.0159 | 0.0053 | 0.0124 | 0.001 | 0.005 | 0.0022 |
| Bud Neck | 0.0245 | 0.0087 | 0.0276 | 0.0123 | 0.0312 | 0.232 | 0.0218 | 0.0126 | 0.047 | 0.0127 | 0.0144 | 0.2233 | 0.0279 | 0.0163 | 0.0449 | 0.0147 | 0.0047 | 0.2429 |
| Bud Periphery | 0.0077 | 0.0025 | 0.0234 | 0.0035 | 0.0109 | 0.0228 | 0.004 | 0.0056 | 0.0128 | 0.0065 | 0.0194 | 0.0137 | 0.0107 | 0.0035 | 0.0158 | 0.0019 | 0.0074 | 0.0091 |
| Bud Site | 0.0571 | 0.1233 | 0.0393 | 0.0025 | 0.0087 | 0.0126 | 0.0321 | 0.147 | 0.0604 | 0.003 | 0.008 | 0.0063 | 0.0358 | 0.1278 | 0.0577 | 0.0019 | 0.0042 | 0.0026 |
| Cell Periphery | 0.0204 | 0.0188 | 0.0095 | 0.003 | 0.0113 | 0.019 | 0.0184 | 0.0098 | 0.012 | 0.0063 | 0.0119 | 0.0127 | 0.0203 | 0.0122 | 0.0115 | 0.0037 | 0.0021 | 0.0147 |
| Cytoplasm | 0.2607 | 0.443 | 0.3181 | 0.1902 | 0.4158 | 0.1665 | 0.3 | 0.3818 | 0.3008 | 0.2817 | 0.2353 | 0.2464 | 0.1915 | 0.3828 | 0.2161 | 0.3496 | 0.1595 | 0.2155 |
| Cytoplasmic Foci | 0.053 | 0.0177 | 0.019 | 0.1032 | 0.0265 | 0.0237 | 0.0386 | 0.031 | 0.0271 | 0.0321 | 0.0761 | 0.0192 | 0.0215 | 0.0099 | 0.0115 | 0.0153 | 0.1285 | 0.0119 |
| Eisosomes | 0.0031 | 0.0016 | 0.0012 | 0.0006 | 0.0018 | 0.0011 | 0.0052 | 0.001 | 0.0058 | 0.0015 | 0.0041 | 0.0025 | 0.0076 | 0.0011 | 0.002 | 0.0067 | 0.0006 | 0.002 |
| Endoplasmic Reticulum | 0.0247 | 0.0099 | 0.0087 | 0.0292 | 0.0301 | 0.0142 | 0.0154 | 0.0051 | 0.0122 | 0.0191 | 0.0198 | 0.0079 | 0.0066 | 0.0138 | 0.0054 | 0.006 | 0.0029 | 0.0095 |
| Endosome | 0.0422 | 0.0063 | 0.0117 | 0.0987 | 0.0213 | 0.0148 | 0.022 | 0.0054 | 0.014 | 0.0361 | 0.0581 | 0.0108 | 0.0195 | 0.001 | 0.0093 | 0.0026 | 0.0369 | 0.0059 |
| Golgi | 0.0322 | 0.0174 | 0.0186 | 0.0672 | 0.0112 | 0.0209 | 0.0323 | 0.0163 | 0.0302 | 0.0341 | 0.0669 | 0.0135 | 0.0144 | 0.0051 | 0.0132 | 0.0239 | 0.0461 | 0.0081 |
| Lipid Particles | 0.025 | 0.0029 | 0.0045 | 0.024 | 0.0062 | 0.0062 | 0.0108 | 0.0012 | 0.0032 | 0.0034 | 0.036 | 0.0063 | 0.0118 | 0.0011 | 0.0031 | 0.0028 | 0.0147 | 0.006 |
| Mitochondria | 0.0222 | 0.0006 | 0.0023 | 0.0235 | 0.0021 | 0.0014 | 0.0063 | 0.0095 | 0.0054 | 0.0212 | 0.0237 | 0.0027 | 0.0027 | 0.0006 | 0.0071 | 0.0007 | 0.0083 | 0.0017 |
| None | 0.0194 | 0.0057 | 0.012 | 0.0024 | 0.0047 | 0.0022 | 0.0115 | 0.0014 | 0.0021 | 0.003 | 0.0041 | 0.0019 | 0.0046 | 0.0024 | 0.0104 | 0.001 | 0.0219 | 0.0052 |
| Nuclear Periphery | 0.0135 | 0.0007 | 0.0008 | 0.0108 | 0.0013 | 0.001 | 0.0016 | 0.0005 | 0.0017 | 0.0045 | 0.0041 | 0.0044 | 0.0036 | 0.0004 | 0.0015 | 0.0003 | 0.0019 | 0.0012 |
| Nucleolus | 0.0054 | 0.0001 | 0.0001 | 0.0004 | 0.0003 | 0.0002 | 0.0007 | 0.0001 | 0.0001 | 0.0001 | 0.0004 | 0.0001 | 0.0004 | 0.0001 | 0.0003 | 0 | 0.0003 | 0.0004 |
| Nucleus | 0.0031 | 0.0006 | 0.0007 | 0.0013 | 0.0013 | 0.0008 | 0.0014 | 0.0021 | 0.0009 | 0.0009 | 0.0013 | 0.0008 | 0.0015 | 0.0005 | 0.0023 | 0.0003 | 0.0011 | 0.0008 |
| Peroxisomes | 0.0146 | 0.0019 | 0.0105 | 0.0785 | 0.0076 | 0.0036 | 0.01 | 0.0083 | 0.0053 | 0.0044 | 0.0281 | 0.0072 | 0.0075 | 0.0016 | 0.0045 | 0.0034 | 0.0165 | 0.0026 |
| Punctate Nuclear | 0.009 | 0.0004 | 0.0013 | 0.0018 | 0.0027 | 0.0014 | 0.0028 | 0.0006 | 0.0007 | 0.0005 | 0.0126 | 0.0009 | 0.0032 | 0.0004 | 0.0016 | 0.0005 | 0.0364 | 0.0011 |
| Vacuole | 0.0048 | 0.0005 | 0.0007 | 0.0051 | 0.0013 | 0.0009 | 0.0018 | 0.0004 | 0.0008 | 0.007 | 0.0023 | 0.0005 | 0.0022 | 0.0002 | 0.0012 | 0.0001 | 0.0007 | 0.0006 |
| Vacuole Periphery | 0.0017 | 0.0001 | 0.0001 | 0.0088 | 0.0002 | 0.0003 | 0.0004 | 0.0001 | 0.0004 | 0.0118 | 0.0009 | 0.0004 | 0.0007 | 0 | 0.0004 | 0 | 0.0003 | 0.0003 |
Sequencing Data
| R1 | R2 | |||||||||
|---|---|---|---|---|---|---|---|---|---|---|
| G1 Post-START | S/G2 | Metaphase | Anaphase | Telophase | G1 Post-START | S/G2 | Metaphase | Anaphase | Telophase | |
| Gene Expression | 30.8498 | 29.9875 | 29.4045 | 43.6995 | 38.0565 | 35.9216 | 45.6159 | 55.9112 | 51.7894 | 47.8344 |
| Translational Efficiency | 1.65 | 1.4711 | 1.5116 | 1.0578 | 1.2121 | 1.6849 | 0.9709 | 1.0443 | 1.1211 | 1.0739 |
Hit Data
| Dataset | Hit |
|---|---|
| Protein Concentration | ✔ |
| Protein Localization | ✘ |
| Gene Expression | ✘ |
| Translational Efficiency | ✘ |
Endocytosis
| Temp | Actin Patch (Sac6-tdTomato) | Cortical Patch (Sla1-GFP) | Late Endosome (Snf7-GFP) | Vacuole (Vph1-GFP) |
|---|---|---|---|---|
| 37℃ | ||||
| RT |
Cell Cycle Omics
CYCLoPs (Ent2-GFP)
| Gene / Allele | Actin Patch (Sac6-tdTomato) | Cortical Patch (Sla1-GFP) | Late Endosome (Snf7-GFP) | Vacuole (Sac6-tdTomato) |
|---|
| Gene | Images |
|---|
| Gene | Images |
|---|
Images are not yet available
Images are not yet available